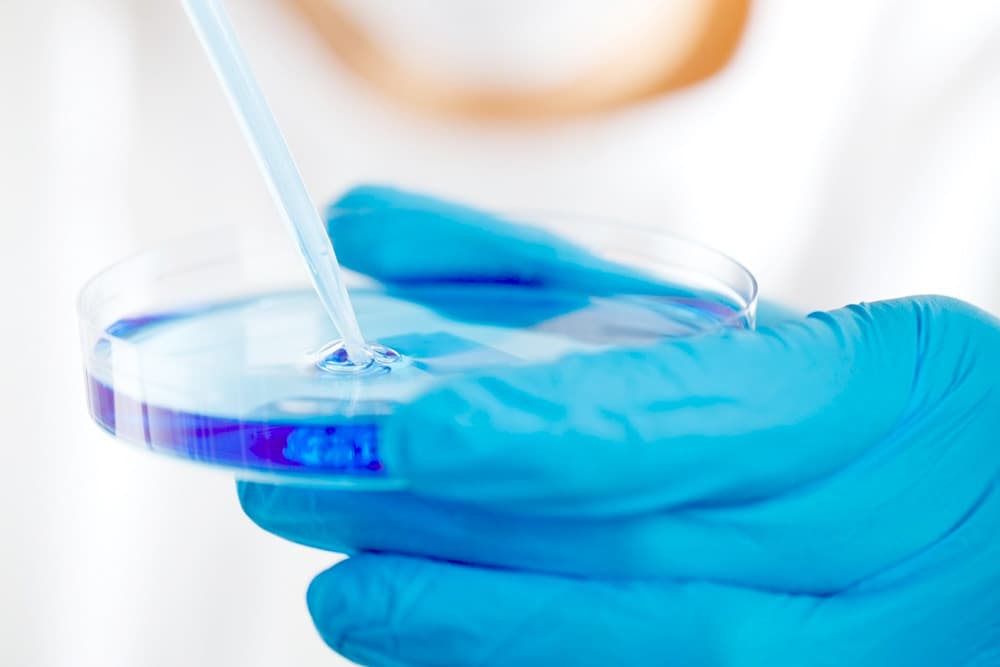

Genética
Introduce un texto aquí...
El estudio de la genética bacteriana revela la base de su capacidad de adaptación y evolución. En este apartado se profundiza en la estructura del material genético, la replicación, mutaciones y la transferencia horizontal de genes. Estos procesos han permitido a las bacterias diversificarse rápidamente, lo que explica en parte la enorme variedad y resiliencia que presentan.
¿Cómo esta compuesto su genoma?
Compuesto por elementos replicativos autónomos, los cuales son el cromosoma, los plásmidos y los bacteriófagos que se describen a continuación. También poseen elementos que presentaban la novedosa propiedad de moverse de un lado a otro de los genomas, pasando de plásmidos a cromosomas o viceversa. Estos elementos móviles resultaron ser unidades genéticas con una amplia diversidad tanto en estructura como en los mecanismos de movilización que utilizan.
Elementos

Cromosoma
Muchas especies bacterianas poseen un único cromosoma que se encuentra superenrollado, aunque hay varias que poseen dos, en general uno de mayor tamaño que otro. Se encuentran en el citoplasma, anclados en la membrana citoplasmática, en una zona que se denomina nucleoide. La mayoría de los cromosomas bacterianos son circulares, si bien existen algunos ejemplos de cromosomas lineales.

Plásmido
Los plásmidos son elementos de ADN doble cadena extracromosomales, circulares o lineales, que se replican independientemente del cromosoma bacteriano. La cantidad de los plásmidos depende del tipo al que pertenezcan, y pueden haber desde una sola copia hasta algunos cientos por bacteria y no contienen información esencial, sino que confieren ventajas al hospedador en condiciones de crecimiento determinadas.

Bacteriófagos
Los bacteriófagos o fagos son los virus que infectan bacterias, y pueden insertarse tanto en el cromosoma como en los plásmidos de la célula huésped. Algunos de los fagos que se insertan en el cromosoma pueden aportar entre sus genes, algún factor de virulencia, tal como es el caso del fago T12 que al infectar e insertarse en cepas de Streptococcus pyogenes puede dar lugar a la enfermedad llamada escarlatina.
Elementos móviles del genoma bacteriano

Necesitan un intermediario de ARN
Estos elementos genéticos utilizan un intermediario de ARN en su movilización intracelular. En las bacterias, se han identificado intrones del grupo I y II que por poseer una transcriptasa reversa y movilizarse en el genoma, son considerados, además de intrones, retrotransposones.
Movilización de ADN a ADN
En estos eventos genéticos, una secuencia de ADN es movilizada y/o copiada de un sitio a otro, ya sea en la misma molécula de ADN o en otra molécula.
Transposones compuestos
Son aquellos transposones que portan alguna función adaptativa (generalmente un mecanismo de resistencia antibiótica) y son de mayor tamaño.
Transposones simples
Son aquellos transposones que tienen largas secuencias repetidas en los extremos (35-40 pares de bases) pero sin secuencias de inserción.
Transposones conjugativos
Presentan la propiedad de promover su diseminación de una bacteria a otra por conjugación. No duplican su secuencia diana al integrarse, y se insertan en cualquier lugar o en un sitio específico del cromosoma o plásmido receptor.
Transferencia horizontal genética
Es el evento por el cual un organismo adquiere material genético de otra célula que no es su progenitor, eventos como la transformación, la conjugación y la trasnducción son característicos de las bacterias.

Uno de sus usos
Un estudio de la Universidad del Estado de Arizona, EE.UU., recientemente publicado en mBio, ha demostrado que bacterias Salmonella de determinado serotipo modificadas genéticamente pueden constituir un vehículo para trasladar compuestos terapéuticos hacia el tejido tumoral, sin dañar al hospedador. en donde, modificaron genéticamente Salmonella typhimurium atenuada para expresar y secretar interferón gamma (IFN-γ) como agente tumoricida, con el fin de mejorar su eficacia terapéutica.